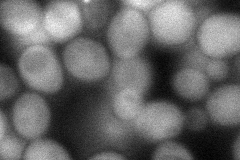
YOR120W
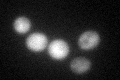
YOR120W
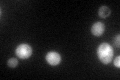
YOR120W

View description
Putative NADP(+) coupled glycerol dehydrogenase, proposed to be involved in an alternative pathway for glycerol catabolism; member of the aldo-keto reductase (AKR) family
Localization:
Intensity:
Fold change:
Significance:
-
C’ GFP library in SD

cytosol37.07 -
N' NOP1pr-GFP in SD

cytosol186.768 -
N' TEF2pr-mCherry in SD

cytosol33.3737 -
N' NATIVEpr-GFP in SD

cytosol39.4756 -
N' TEF2pr-VC and Cyto-VN in SD
cytosol68.8461 -
C’ GFP library in SD+DTT

cytosol71.941.94Yes -
C’ GFP library in SD+H2O2
cytosol73.051.97Yes -
C’ GFP library in Starvation Media
cytosol143.773.87Yes -
C’ GFP library on the background of Pup2-DaMP

cytosol -
C’ GFP library on the background of CCT mutant

cytosol45.46041.22595No
